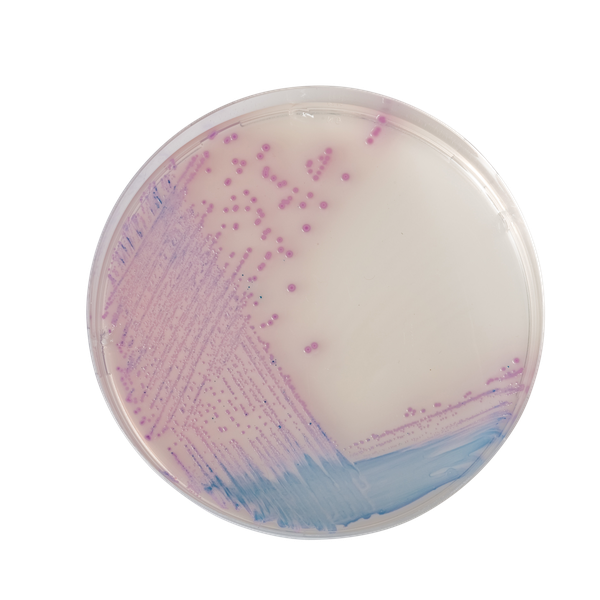
CHROMagar™ Salmonella
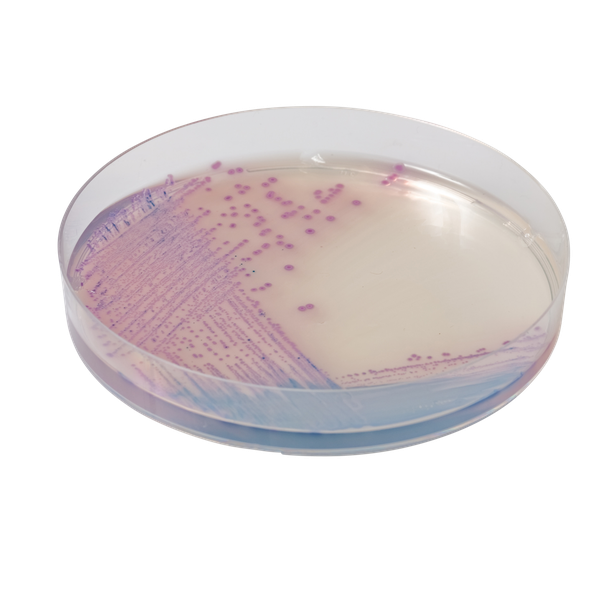
CHROMagar™ Salmonella

Hình thái khuẩn lạc

Salmonella bao gồm S. Typhi
Màu tím nhạt

Các vi khuẩn khác
Màu xanh, không màu hoặc bị ức chế
Hiệu năng
Hiệu năng
Nhiễm khuẩn gây bởi Salmonella spp, bao gồm Salmonella Typhi, tiếp tục là vấn đề sức khỏe lớn trên toàn cầu:
• Ở Mỹ, Salmonella có tỷ lệ mắc bệnh là 16.47 trường hợp trên 100,000 người (ước tính CDC, 2010).
• Ở Châu Âu, nó được báo cáo như nguyên nhân vi khuẩn hàng đầu gây bùng phát dịch thực phẩm (báo cáo EFSA/ECDC 2011, số liệu 2009)
• Ở các nước đang phát triển, Salmonella Typhi và Paratyphi thường xuất hiện với ước tính tỷ lệ mắc bệnh hàng năm khoảng 17 triệu trường hợp (báo cáo EFSA 2007)
Hơn nữa, theo một báo cáo gần đây của WHO, nhiễm Salmonella là nguyên nhân cho 2 triệu ca tử vong mỗi năm do tiêu chảy. Salmonella là nhiễm trùng động vật truyền sang người được báo cáo nhiều thứ hai (báo cáo EFSA/ECDC 2011, số liệu 2009).
Chủ yếu do ô nhiễm trong chuỗi thực phẩm và/hoặc trong các quá trình sản xuất thực phẩm, Salmonella thường gây ra bệnh đường ruột với các triệu chứng chính là đau quặn bụng, tiêu chảy, buồn nôn, nôn. Các trường hợp nặng hơn, ví dụ như thương hàn hoặc nhiễm trùng
Mục đích sử dụng :
CHROMagar™ Salmonella là môi trường nuôi cấy chọn lọc chromogen được sử dụng để phát hiện định tính trực tiếp, phân biệt, và nhận diện sơ bộ Salmonella. Xét nghiệm được thực hiện với mẫu quẹt trực tràng và phân, hỗ trợ chẩn đoán nhiễm Salmonella. Kết quả có thể được giải thích sau 18-24 giờ ủ hiếu khí ở 35-37 °C.
Nuôi cấy đồng thời là cần thiết để thu hồi vi sinh vật phục vụ cho xét nghiệm vi sinh học hoặc xác định dịch tễ học thêm. Việc thiếu sự phát triển hoặc không có khuẩn lạc màu tím hồng trên CHROMagar™ Salmonella không loại trừ sự hiện diện của Salmonella.
CHROMagar™ Salmonella không được dùng để chẩn đoán nhiễm trùng hay hướng dẫn, kiểm soát điều trị nhiễm trùng.
CHROMagar™ Salmonella cũng có thể được sử dụng trong phát hiện Salmonella trong phân tích các sản phẩm thực phẩm để tiêu thụ của con người, thức ăn gia súc và trong các mẫu môi trường.
1. Dễ đọc : Màu khuẩn lạc tím hồng đậm giúp nhận dạng dễ dàng và ức chế một phần E. coli và các coliform.
2. Tính đặc hiệu cao hơn / ít khối lượng công việc :Các môi trường truyền thống để phát hiện Salmonella theo đặc tính H2S có độ đặc hiệu rất kém, dẫn đến nhiều kết quả dương tính giả. (Citrobacter, Proteus, v.v.) trong số ít dương tính thật với Salmonella. Khối lượng công việc cho việc kiểm tra không cần thiết các khuẩn lạc nghi ngờ rất nhiều, khiến các khuẩn lạc Salmonella dương tính thật có thể bị bỏ sót trong kiểm tra định kỳ.
Do độ đặc hiệu kém, các môi trường truyền thống yêu cầu kiểm tra tỉ mỉ ít nhất 10 khuẩn lạc cho mỗi mẫu nghi ngờ. Ngược lại, CHROMagar™ Salmonella loại bỏ hầu hết các dương tính giả đó và cho phép các kỹ thuật viên tập trung vào các mẫu bị nhiễm thực sự.
3.Độ nhạy và đặc hiệu cao dẫn đến tỷ lệ phát hiện Salmonella cao hơn
Dữ liệu phân tích
- Độ nhạy : (81 %) và 93 % *
- Độ đặc hiệu : 100 %
Dữ liệu lâm sàng
- Độ nhạy : 95 %*
- Độ đặc hiệu : 88,9 %* so với 78,5 % với Hektoen Agar
* Dữ liệu nội bộ thu được sau khi ủ 24-48 giờ ở 37 °C trong điều kiện hiếu khí. Tỷ lệ % độ nhạy trong ngoặc bao gồm các loài Salmonella dương tính với lactose phát triển trong màu xanh. 2012.
** Dữ liệu thu được sau khi ủ 18-24 giờ ở 37 °C trong điều kiện hiếu khí với 508 mẫu phân được phân tích trong nghiên cứu “So sánh môi trường CHROMagar™ Salmonella và Hektoen Enteric Agar cho việc phân lập Salmonellae từ các mẫu phân“. Gaillot et al., 1998. J. Clin. Microbiol.
4. Giảm đáng kể khối lượng công việc : Số lượng kiểm tra xác nhận không cần thiết được giảm thiểu do không cần phải lặp lại chúng.
Thành phần

Tài liệu kỹ thuật
Công bố khoa học
2004
Development of a novel cross-streaking method for isolation, confirmation, and enumeration of Salmonella from irrigation ponds
📄 Publication2003
Comparison of four chromogenic media and Hektoen Agar for detection and presumptive identification of Salmonella strains in human stools
📄 Publication2002
Comparison of CHROMagar Salmonella medium and Xylose-Lysine-Desoxycholate and Salmonella-Shigella Agars for isolation of Salmonellae from stool samples.
📄 Publication1999
Comparison of CHROMagar Salmonella medium and Hektoen Enteric Agar for isolation of Salmonellae from stool samples
📄 Publication2011
Rapid detection of Salmonella in Chicken meat using immunomagnetic separation, CHROMagar, Elisa and Real-time Polymerase Chain Reaction (RT-PCR)
📄 Publication2006
Salmonella Prevalence and Total Microbial and Spore Populations in Spices Imported to Japan
📄 Publication2005
Evaluation of three enrichment broths and five plating media for Salmonella detection in poultry
📄 Publication

Xem thêm